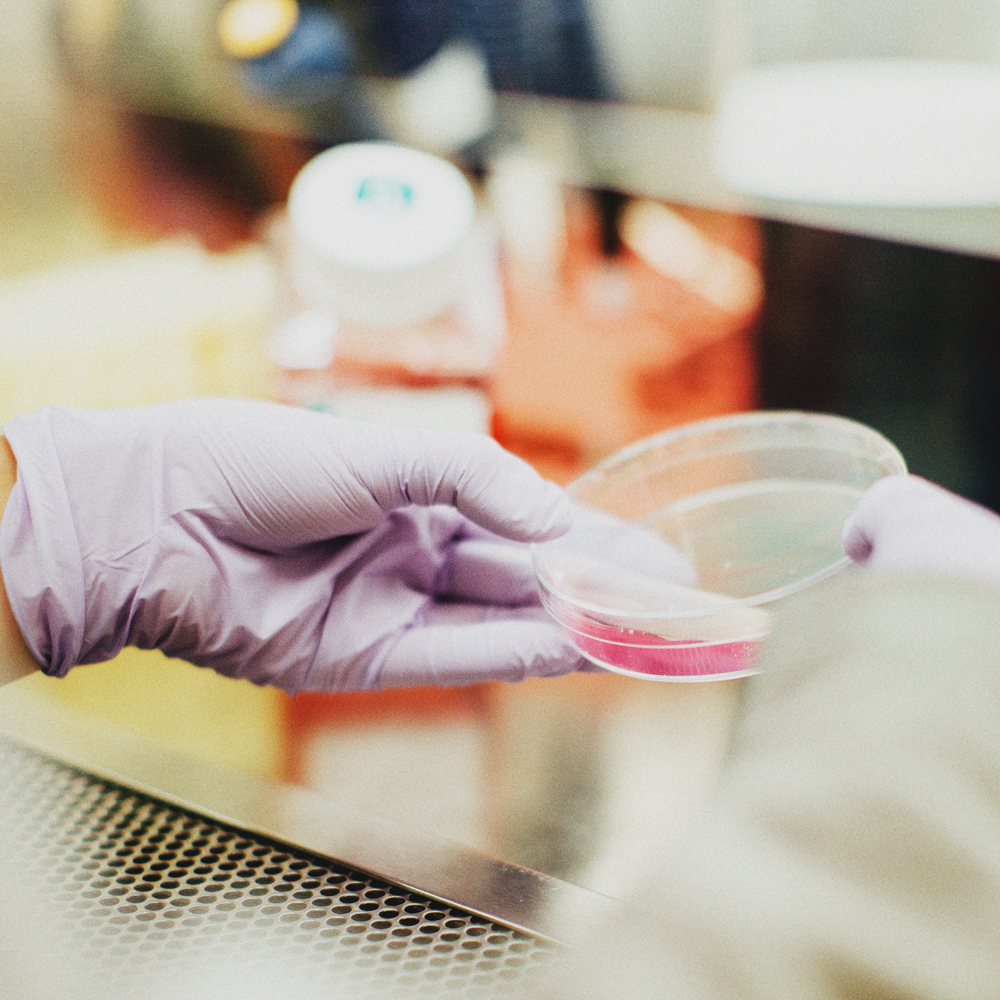

Bolt Burdon Kemp Site Improvements
Increasing Bolt Burdon Kemp’s organic site sessions by 65% year-on-year through on-site optimisations and targeted content campaigns
We use cookies to ensure that we give you the best experience on our website. If you continue without changing your settings, we'll assume that you're happy to receive all cookies from this website. Find out more.

Increasing Bolt Burdon Kemp’s organic traffic by 199% through SEO, conversion rate optimisation, UX, content marketing, and digital PR activity